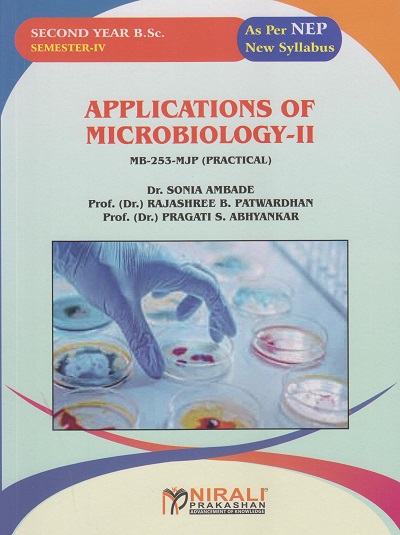
APPLICATIONS OF MICROBIOLOGY 2 : MB-253-MJP (Practical) for SY BSc Semester 4 | Dr. Sonia Ambade | Nirali Prakashan

BSc / BSc CS / BSc CA / MSc CA / MSc CS Textbooks (Science)
1990 titles found

COMMUNICATION ELECTRONICS for SY BSc (Electronic Science) Semester 4 | S.R. Chaudhari | Nirali Prakashan
1. Basics of Electronic Communication 2. Analog Modulation Techniques 3. Pulse Modulation Techniques 4. Application of Communication Syst...

ADVANCE COMMUNICATION for SY BSc (Computer Science) Semester 4 | Dr. Jayashri A. Bangali | Nirali Prakashan
1. Introduction to Communication System 2. Digital Modulation, Multiplexing and Spread Spectrum Techniques 3. Cellular and Satellite Commu...

PRACTICALS IN MODERN ZOOLOGICAL TECHNIQUES AND INSTRUMENTATION 2 (ZOO-293-MNP) for SY BSc Semester 4 | Dr. Kishore R. Pawar | Nirali Prakashan

ORGANIC AND ANALYTICAL CHEMISTRY PRACTICAL (Practical Chemistry: CHE-292-P MNP) for SY BSc Semester 4 | Prof. Dr. Gulab S. Gugale | Nirali Prakashan
APPLICATIONS OF MICROBIOLOGY 2 : MB-253-MJP (Practical) for SY BSc Semester 4 | Dr. Sonia Ambade | Nirali Prakashan

INDUSTRIAL CHEMISTRY PRACTICAL 1 (Practical Chamistry: CHE-271-P VSC) for SY BSc Semester 4 | Prof. Dr. Gulab S. Gugale | Nirali Prakashan

AIR AND WATER MICROBIOLOGY (MB-252-MJ) for SY BSc Semester 4 | Prof. Dr. Pragati S. Abhyankar | Nirali Prakashan
CREDIT I: Air Microbiology 1. Introduction to Air Microbiology 2. Airborne Infections (The Types of Airborne Pathogens with Respect to Cau...

ORGANIC AND ANALYTICAL CHEMISTRY (CHE-291-T-MN: Minor) for SY BSc Semester 4 | Prof. Dr. Manisha A. Bora | Nirali Prakashan
1. Structure, Acidity and Basicity 2. Reactivity and Reaction of Halogenated Hydrocabons 3. Volumetric Analysis 4. Chromatography

ADVANCE NETWORK SECURITY for SY BSc (Cyber and Digital Science) Semester 4 | Dr. Ms. Manisha Bharambe | Nirali Prakashan
1. Introduction to Network Security 2. Cryptographic Techniques 3. Network Security Protocols 4. Intrusion Detection and Prevention 5. W...

ETHICAL HACKING 2 for SY BSc (Cyber and Digital Science) Semester 4 | Dr. Shveti Chandan | Nirali Prakashan
1. Wireless & IoT Hacking 2. Exploiting Systems Using Metasploit 3. Social Engineering and Phishing Attacks 4. Malware Analysis and R...

CHEMISTRY PRACTICAL 4 (CHE-253-P MJP) for SY BSc Semester 4 | Prof. Dr. Gulab S. Gugale | Nirali Prakashan

